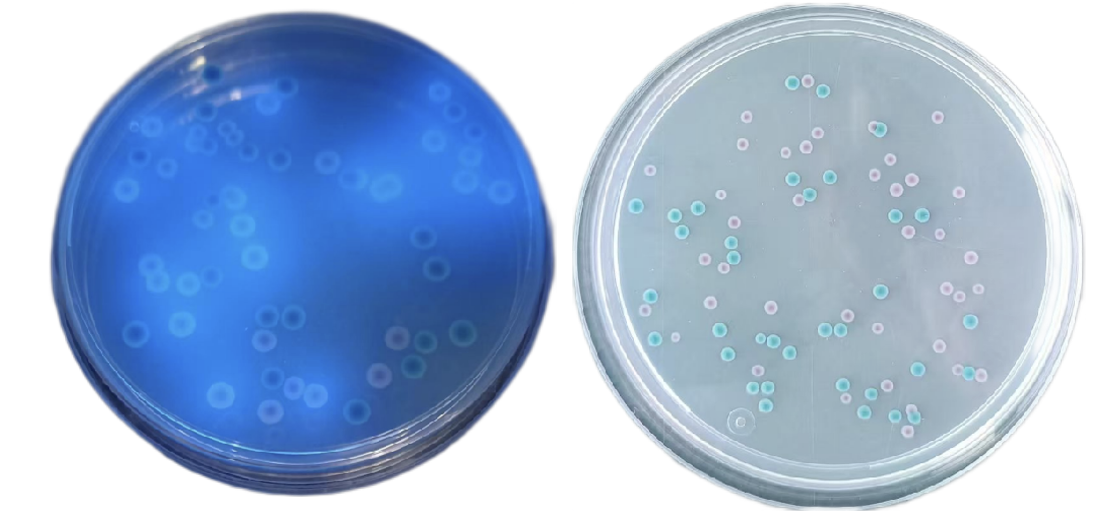

CRM021C Chromogenic Shgia toxin-producing Escherichia coli (STEC) medium
$558-857
Intended Use For the isolation of Shiga toxin-producing Escherichia coli (STEC). Principle and Interpretation Peptone and yeast extract provide nitrogen, carbon sources, long-chain amino a……
Introduction
Intended Use
For the isolation of Shiga toxin-producing Escherichia coli (STEC).
Principle and Interpretation
Peptone and yeast extract provide nitrogen, carbon sources, long-chain amino acids, vitamins, and essential nutrients.Chromogenic mixture reacts with STEC, producing purple-red to violet colonies.STEC O157:H7: Purple colonies, no fluorescence.Non-O157 STEC serotypes: Purple colonies with fluorescence (rare strains may lack fluorescence).Other Enterobacteriaceae: Colorless or blue colonies, or inhibited.Selective additives suppress Gram-positive bacteria and other contaminants.
Formulation
| Ingredients | /liter |
| Beef peptone + yeast extract | 8.0 g |
| Salts | 5.2 g |
| Chromogenic agent | 2.6 g |
| Agar | 15.0 g |
| pH 6.9±0.2 at 25°C | |
Preparation
Weigh 30.8 g of the medium base and dissolve in 1 L of distilled or deionized water.Stir and heat to boiling until fully dissolved.Cool to 50°C, then add 1 tube of supplementary reagent (SR0820) per 100 mL medium. Mix thoroughly.Pour into sterile Petri dishes and allow to solidify.
Performance Characteristics
STEC O157:H7: Pale purple colonies, no fluorescence.
Non-O157 STEC: Pale purple colonies with fluorescence.
Non-STEC E. coli: No growth or weak growth (rare strains may show purple colonies).
Other Enterobacteriaceae: Blue colonies.
Confirmation: Colonies must be further tested via serological or molecular methods.
Quality Control
Cultural characteristics observed after incubation at 35-37°C for 24 hours
| Quality control strains | Approx. Inoculum(CFU) | Recovery | Characteristics |
| Escherichia coli CMCC(B)44939 | 10-100 | PR≥0.7 | Pale purple colonies, no fluorescence |
| Citrobacter freundii CMCC(B)43228 | 10-100 | PR≥0.7 | Pale purple colonies, fluorescence |
| Salmonella typhimurium ATCC 25922 | > 104 | G≤1 | No growth |
| Enterococcus faecalis ATCC29212 | > 104 | G≤1 | No growth |
Storage and Shelf Life
2-30℃,Keep container tightly closed, avoid direct sunlight.
Use before expiry date on the label.
Precautions
1. When weighing the dehydrated medium, please wear masks to avoid causing respiratory system discomfort
2. Keep container tightly closed after using to prevent clumping.
Waste Disposal
Microbiological contamination was disposed by autoclaving at 121°C for 30 minutes.
Revision
On June 14, 2024
Shiga toxin-producing Escherichia coli (STEC): Pale purple colonies, no fluorescence
Non-STEC Escherichia coli: Pale purple colonies, fluorescent
Other Enterobacteriaceae: Colorless/blue colonies or inhibited/no growth



